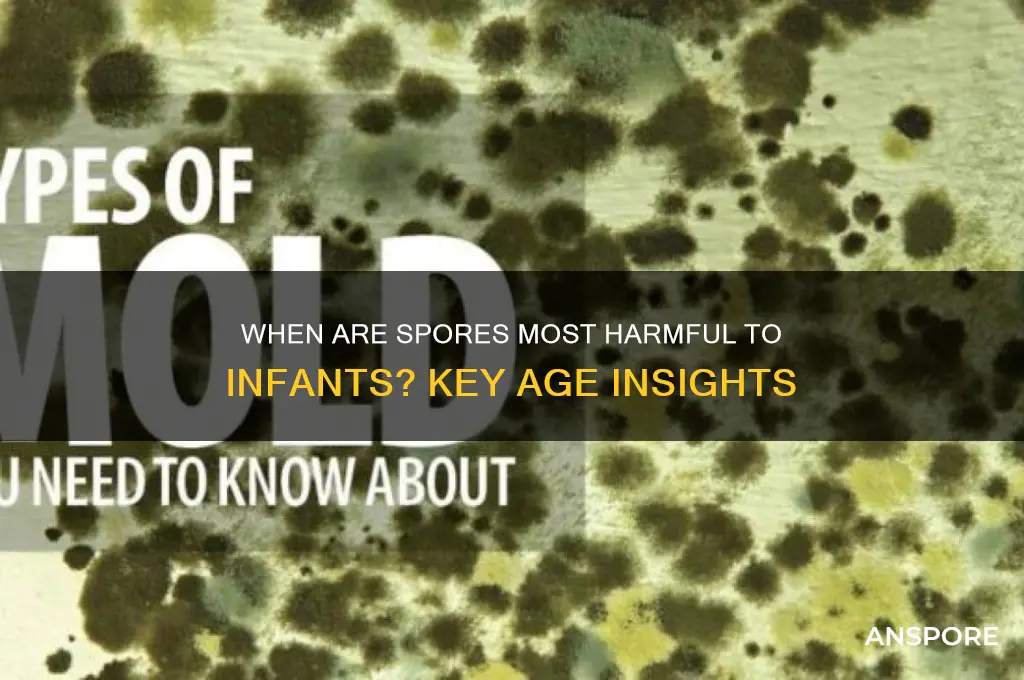
what age do spores hurt baby most

The question of at what age spores, particularly mold spores, can be most harmful to babies is a critical concern for parents and caregivers. Infants, especially those under one year of age, are more susceptible to the adverse effects of mold exposure due to their developing immune systems and immature respiratory systems. During the first six months, babies are at the highest risk, as their bodies are still building defenses against environmental allergens and irritants. Prolonged exposure to mold spores during this period can lead to respiratory issues, allergies, and in severe cases, more serious health complications. Understanding this vulnerability is essential for creating a safe and healthy environment for infants.
What You'll Learn
- Early Infancy Vulnerability: Newborns to 3 months are most susceptible due to underdeveloped immune systems
- Respiratory Risks: Spores can severely impact babies’ lungs, causing infections like pneumonia
- Immune System Development: Babies’ immunity strengthens by age 2, reducing spore-related harm
- Environmental Exposure: Indoor mold spores pose higher risks in poorly ventilated spaces
- Symptoms to Watch: Persistent coughing, wheezing, or skin rashes indicate spore-related issues

Early Infancy Vulnerability: Newborns to 3 months are most susceptible due to underdeveloped immune systems
Newborns to 3-month-olds face heightened vulnerability to spore-related health risks due to their underdeveloped immune systems. During this critical period, their bodies are still learning to distinguish between harmless and harmful invaders, making them particularly susceptible to infections caused by mold spores, fungal pathogens, and other airborne particulates. For instance, *Aspergillus* and *Penicillium* spores, commonly found in damp environments, can trigger respiratory distress or allergic reactions in infants whose immune responses are not yet fully equipped to handle such threats.
Analytical Insight: The immune system of a newborn is functionally immature, lacking sufficient memory cells and antibodies to combat foreign agents effectively. Studies show that infants under 3 months old are 3–5 times more likely to develop spore-related illnesses, such as bronchopulmonary aspergillosis or allergic bronchopulmonary mycosis, compared to older children. This susceptibility is compounded by their increased respiratory rate (40–60 breaths per minute) and proximity to indoor surfaces where spores accumulate, such as carpets, curtains, and humidifiers.
Practical Steps for Parents: To mitigate risks, maintain indoor humidity below 50% using dehumidifiers, and regularly clean areas prone to mold growth, such as bathrooms and kitchens. Avoid using humidifiers in nurseries unless equipped with sterile water, as standing water can become a breeding ground for spores. If mold is detected, remove the source promptly and consult a professional for remediation. For infants showing symptoms like persistent coughing, wheezing, or skin rashes, seek medical attention immediately, as early intervention can prevent complications.
Comparative Perspective: Unlike older children, whose immune systems can often neutralize spore exposure without clinical symptoms, infants may experience severe reactions even from low spore counts. For example, exposure to 1,000 spores/m³ of *Stachybotrys chartarum* (black mold) can cause respiratory irritation in adults but may lead to systemic inflammation or fungal pneumonia in newborns. This disparity underscores the need for age-specific environmental precautions during early infancy.
Takeaway: Protecting newborns from spore exposure is not just about cleanliness but about creating a controlled environment that compensates for their biological limitations. By understanding the unique vulnerabilities of this age group, caregivers can implement targeted measures to safeguard their health during the first three months of life, when their immune systems are most fragile.
Transferring Spores to Avalanche: A Step-by-Step Guide for Beginners
You may want to see also

Respiratory Risks: Spores can severely impact babies’ lungs, causing infections like pneumonia
Babies under 12 months, especially those under 6 months, face heightened respiratory risks from spore exposure due to their immature immune systems and developing lungs. Spores from mold, fungi, or other sources can infiltrate their airways more easily, leading to severe infections like pneumonia. Unlike older children or adults, infants lack the immune defenses to combat these invaders effectively, making them particularly vulnerable during this critical developmental stage.
Consider the mechanics of spore inhalation in infants. Their smaller airways mean even a small number of spores can cause significant obstruction or irritation. For instance, mold spores as small as 2-10 microns can reach the deepest parts of a baby’s lungs, triggering inflammation and infection. Practical prevention includes maintaining indoor humidity below 50%, regularly cleaning damp areas, and avoiding carpeting in nurseries, as these steps reduce spore proliferation in the baby’s immediate environment.
Comparatively, older children and adults typically experience milder respiratory symptoms from spore exposure, such as coughing or sneezing. In babies, however, the same exposure can escalate rapidly to pneumonia, bronchitis, or asthma-like symptoms. A study in *Pediatrics* highlights that infants exposed to mold spores are 30% more likely to develop respiratory infections within the first year. This underscores the urgency of minimizing spore exposure during infancy, particularly in the first six months when lung tissue is most fragile.
To protect babies, caregivers should monitor for early warning signs of spore-related respiratory issues: persistent coughing, wheezing, rapid breathing, or labored chest movements. If these symptoms appear, seek medical attention promptly, as early intervention with antibiotics or bronchodilators can prevent complications. Additionally, using HEPA air filters in the baby’s room and ensuring proper ventilation during activities like cooking or bathing can significantly reduce spore concentration in the air.
In summary, spores pose a disproportionate threat to babies’ respiratory health, particularly in the first year of life. By understanding the unique risks, recognizing early symptoms, and implementing targeted preventive measures, caregivers can safeguard infants from severe lung infections. Vigilance and proactive environmental management are key to protecting this vulnerable age group.
Does TB Have Spores? Unraveling the Mycobacterium Tuberculosis Mystery
You may want to see also

Immune System Development: Babies’ immunity strengthens by age 2, reducing spore-related harm
Babies are born with an immature immune system, leaving them vulnerable to various environmental threats, including spores from mold, fungi, and other microorganisms. During the first year of life, their immune responses are primarily mediated by innate immunity, which is less specific and less effective against a wide range of pathogens. This developmental stage makes infants more susceptible to spore-related illnesses, such as respiratory infections or allergic reactions, as their bodies struggle to distinguish between harmful and harmless substances.
By age 2, a child’s immune system undergoes significant maturation, particularly in the adaptive immune response. This includes the development of T cells and B cells, which provide targeted defense mechanisms against specific pathogens. For instance, exposure to common environmental spores begins to trigger the production of antibodies, reducing the likelihood of severe reactions. Studies show that the risk of spore-induced asthma or allergies decreases markedly after this age, as the immune system learns to tolerate or neutralize these foreign particles more effectively.
Practical steps can be taken to minimize spore exposure during this critical period. Keep indoor humidity below 50% to inhibit mold growth, and regularly clean areas prone to moisture, such as bathrooms and kitchens. Avoid using carpet in damp spaces, as it can harbor spores. For infants under 2, ensure their environment is well-ventilated and free from visible mold. If spore exposure is suspected, consult a pediatrician, especially if the child exhibits symptoms like persistent coughing, wheezing, or skin rashes.
Comparatively, older children and adults benefit from years of immune system training, which allows them to handle spore exposure with minimal adverse effects. However, for babies, the window of vulnerability is highest in the first 12–18 months, when their immune systems are still learning to differentiate between threats and benign substances. This underscores the importance of proactive environmental management during this stage to protect their developing immunity.
In conclusion, while spores pose a heightened risk to babies under 2 due to their immature immune systems, the natural strengthening of immunity by this age significantly reduces potential harm. By understanding this developmental timeline and implementing practical precautions, parents and caregivers can create a safer environment for infants during their most vulnerable months.
Annual Academy Sports Openings: How Many Launch Each Year?
You may want to see also

Environmental Exposure: Indoor mold spores pose higher risks in poorly ventilated spaces
Infants and young children are particularly vulnerable to the adverse effects of indoor mold spores, especially in poorly ventilated environments. Mold spores, which are microscopic and easily inhaled, can trigger respiratory issues, allergies, and other health problems in babies whose immune systems are still developing. The risk is heightened in spaces where air circulation is limited, allowing mold to thrive and concentrate in the air. For instance, a study published in *Indoor Air* found that infants living in moldy, poorly ventilated homes were 40% more likely to develop asthma by age 7 compared to those in well-ventilated homes.
To mitigate these risks, parents and caregivers must focus on improving indoor air quality. Start by identifying and addressing moisture sources, such as leaks or condensation, which are breeding grounds for mold. Use dehumidifiers to maintain humidity levels below 50%, as mold thrives in damp conditions. Regularly clean areas prone to moisture, like bathrooms and kitchens, with mold-inhibiting solutions. Ensure proper ventilation by opening windows, using exhaust fans, or installing air exchange systems, particularly during activities like cooking or showering that increase humidity.
Age-specific precautions are crucial. Babies under 12 months, especially those with a family history of allergies or asthma, are most susceptible due to their immature respiratory and immune systems. For this age group, avoid placing cribs near windows with condensation or damp walls. Use air purifiers with HEPA filters in the nursery to reduce spore counts. For toddlers (ages 1–3), monitor their play areas for hidden mold, such as under carpets or behind furniture, as they spend more time on the floor and are prone to putting objects in their mouths.
Comparatively, older children may exhibit clearer symptoms of mold exposure, such as persistent coughing or skin rashes, but infants often show subtler signs like irritability, frequent respiratory infections, or wheezing. This makes proactive prevention even more critical. Regularly inspect your home for mold, focusing on hidden areas like basements, attics, and behind appliances. If mold is detected, professional remediation may be necessary to ensure complete removal and prevent recurrence.
In conclusion, protecting infants from indoor mold spores requires a multi-faceted approach centered on ventilation, moisture control, and vigilant monitoring. By taking these steps, caregivers can significantly reduce the risk of mold-related health issues, ensuring a safer environment for babies during their most vulnerable developmental stages. Remember, prevention is key—small changes in home maintenance can yield substantial health benefits for your child.
Can Mold Spores Appear in Urine After a Month of Exposure?
You may want to see also

Symptoms to Watch: Persistent coughing, wheezing, or skin rashes indicate spore-related issues
Infants and young children are particularly vulnerable to the effects of spores due to their developing immune systems and immature respiratory tracts. Among the most concerning symptoms of spore exposure are persistent coughing, wheezing, and skin rashes, which can signal underlying health issues that require immediate attention. These symptoms often manifest in children under the age of 2, as their bodies are still learning to combat environmental irritants. For instance, mold spores, commonly found in damp environments, can trigger prolonged coughing fits in babies as young as 6 months old, especially if they have a genetic predisposition to allergies or asthma.
Analyzing the connection between age and symptom severity reveals a critical window of susceptibility. Between 6 and 18 months, babies are at peak risk because their airways are narrower, making them more prone to inflammation from spore inhalation. Wheezing, a high-pitched whistling sound during breathing, is a red flag during this period. It often indicates bronchial constriction, which can escalate into respiratory distress if left untreated. Parents should monitor for recurrent wheezing episodes, particularly after exposure to dusty or moldy areas, and consult a pediatrician if symptoms persist beyond 48 hours.
Skin rashes linked to spore exposure, such as hives or eczema flare-ups, are another symptom to watch for, especially in infants aged 3 to 12 months. Their skin barrier is less developed, allowing allergens like pollen or fungal spores to penetrate more easily. A rash that spreads rapidly, is accompanied by itching, or persists for more than 3 days warrants medical evaluation. Topical treatments like hypoallergenic moisturizers can provide temporary relief, but identifying and eliminating the spore source is crucial for long-term management.
Practical steps can mitigate spore-related risks. For children under 2, maintain indoor humidity below 50% to discourage mold growth, and regularly clean areas prone to dampness, such as bathrooms and kitchens. Use HEPA filters in vacuums and air purifiers to reduce airborne spores. During pollen seasons, keep windows closed and bathe babies before bedtime to remove allergens from their skin and hair. Early intervention, combined with environmental vigilance, can significantly reduce the impact of spores on vulnerable infants.
Mastering Morel Spores: A Beginner's Guide to Collection Techniques
You may want to see also
Frequently asked questions
Babies are most vulnerable to spores during their first year of life, particularly in the first six months, as their immune systems are still developing.
Yes, spores from mold or fungi can harm newborns, as their immune systems are underdeveloped, making them more susceptible to infections and respiratory issues.
Spores pose the highest risk to infants between 0 and 6 months old, when their immune defenses are weakest and their respiratory systems are most sensitive.
Yes, babies under 1 year old are more affected by spores than older children due to their immature immune systems and smaller airways, which can lead to severe respiratory problems.
Parents should be most concerned about spore exposure during the first 6–12 months of a baby's life, as this is when their bodies are least equipped to handle potential infections or irritants from spores.







